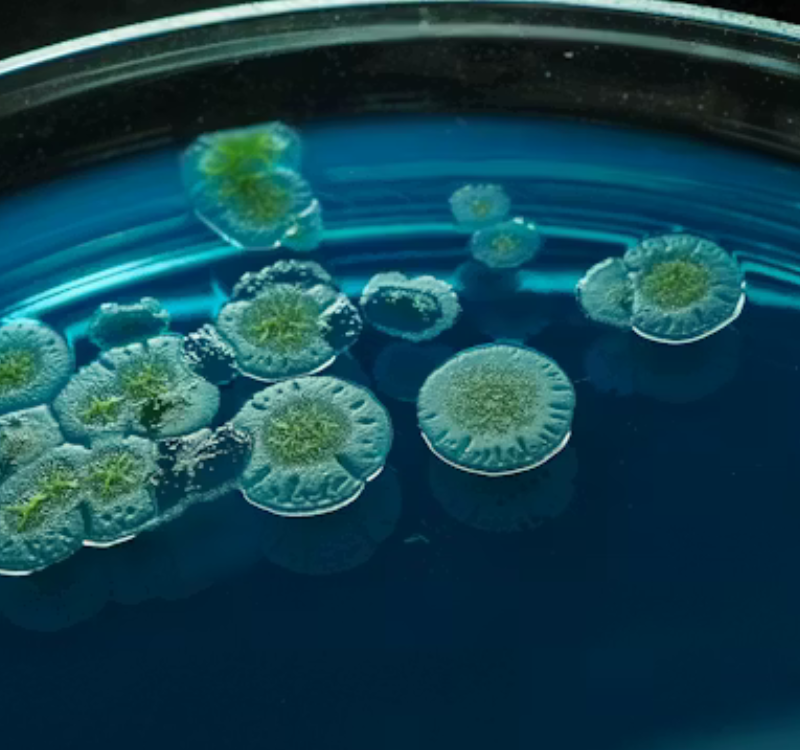
12

Global Cleanroom Manufacturers & Turnkey Cleanroom Solutions
Design | Engineering | Manufacturing | Installation | Validation
Your Environment, Our Expertise
Modular Cleanroom Manufacturers You Can Trust
As modular cleanroom manufacturers, Aastha Cleanrooms engineers, design, and deliver turnkey cleanroom solutions that meet global standards of performance and compliance. With in-house cleanroom manufacturing, we reduce external dependency and ensure superior materials, consistent quality control, and precision throughout every stage of the project.
Industries We Serve
Connect with us
Let’s work together to create a clean environment.
We design and deliver modular cleanrooms, labs, and controlled environments built for reliability and compliance.
Our experts will reach out to guide your project and initiate your turnkey journey with ease.
Call us for inquiry:
Monday to Saturday: 9:30 am – 6:00 pm
+91 96199 02276
+91 90292 63615
Frequently Asked Questions